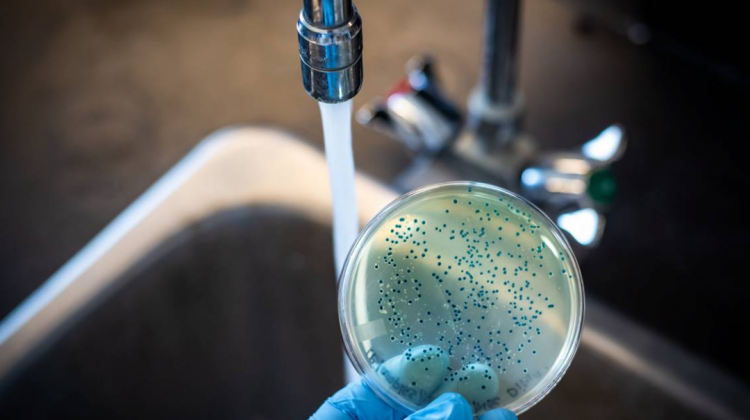

🔵 #ANF | #Internacional La OMS alerta de que el cambio climático potencia el resurgimiento del cólera en todo el mundo
Lea la nota completa aquí ► https://t.co/bFJJofjUTQ pic.twitter.com/PAyC0V4DxG— Agencia de Noticias Fides (@noticiasfides) October 6, 2022
🔵 #ANF | #Internacional La OMS alerta de que el cambio climático potencia el resurgimiento del cólera en todo el mundo
Lea la nota completa aquí ► https://t.co/bFJJofjUTQ https://t.co/PAyC0V4DxG
=> Recibir por Whatsapp las noticias destacadas